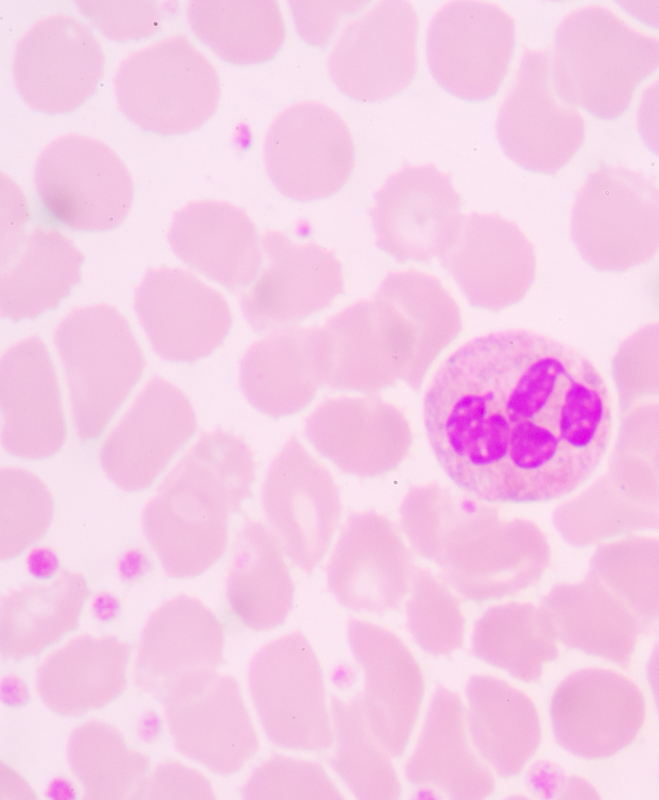

One treatment, many options
Whether you’re looking to improve your back pain, treat hair loss or simply rejuvenate and brighten the complexion, PRP can help bring your dreams to life. This minimally invasive procedure offers effective, natural-looking, long-lasting results - all with minimal recovery time.

Rejuvenate your skin
Acne scars, stretch marks, uneven skin tone, fine lines, and wrinkles don’t have to be permanent. Platelet-rich plasma therapy provides noticeable and lasting results, helping you look and feel your best without surgery.

Treat injuries
Gives your body the power to heal itself smarter and faster with no risk of surgical complications. PRP can provide long-term relief for many common injuries or conditions, including sprained knees, back pain, tendonitis, golf, and tennis elbow.

Regenerate natural, healthy hair
Another stroke of the hairbrush, another visible patch of the scalp, and another handful of strands. Hair loss can be tough, but there’s a solution. Thanks to life-changing PRP treatments, hundreds of our patients gained profound confidence with thicker, fuller hair.
Real people, real results
PRP injections for rotator cuff tear and tinnitus in my elbow-WOW! Restoration in both is amazing, planning my next injection soon. Wonderful results with every visit and treatment! -Terri L
Doctors told me I needed double knee replacement. When I came to Sparrow I was in a wheelchair and yesterday I was able to WALK unassisted and worked in my shop! Thank you! -Frank C
What on earth is PRP?
PRP is a natural substance derived from a small sample of your own blood. It contains a variety of healing factors, such as white blood cells and growth factors. To simulate a natural repair process, platelet-rich plasma is retracted from blood and injected directly into the area of concern. This process is safe, fast, and has little to no downtime.

Frequently Asked Questions
Here to Serve A 5-Star Experience
At Sparrow, we combine state-of-art treatments with unparalleled expertise to help all our clients get their desired results. Because every patient is different, we provide a personalized treatment plan for each one. Our friendly team will listen to your every concern and guide you through every step of your healing journey.